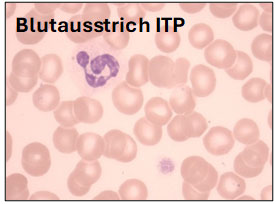
Blutausstrich ITP

ASH Kurier für ITP Patientinnen und Patienten
für Sie erstellt von Sonja Alesci, Axel Matzdorff, Thomas Stauch, Karolin Trautmann-Grill
Jedes Jahr im Dezember findet der Jahreskongress der American Society of Hematology statt (das ist die Amerikanische Fachgesellschaft für Blutkrankheiten, wer das googeln möchte: ASH Annual Meeting, https://www.hematology.org/meetings). Mit über 30.000 Teilnehmern ist das der größte Kongress für Blutkrankheiten weltweit. Hier werden jedes Jahr die neuesten Entwicklungen und Medikamente vorgestellt. Aber es geht nicht nur um neue Medikamente, auch Lebensqualität, Nebenwirkungen von Therapien und wir man all das mit den Patienten kommuniziert sind wichtige Themen. Dieses Jahr gab es wieder viele Vorträge zur ITP. Im Folgenden wollen wir Ihnen eine Auswahl vorstellen.
| Wichtige Anmerkung: Die in diesem Dokument bereitgestellten Informationen dienen ausschließlich der allgemeinen Aufklärung und Information. Sie stellen keine medizinische Beratung, Diagnose oder Behandlungsempfehlung dar. Diese Informationen können und sollen den Besuch bei einem qualifizierten Arzt oder Therapeuten nicht ersetzen. Wenden Sie sich bei gesundheitlichen Fragen oder Beschwerden immer persönlich an den Arzt Ihres Vertrauens. Nehmen Sie niemals Medikamente oder Behandlungen eigenständig ein, setzen diese ab oder ändern sie ohne ärztliche Rücksprache ein. |
Die neue ITP-Leitlinie der American Society of Hematology
Seit 1996 veröffentlich die American Society of Hematology regelmäßig Leitlinien zur ITP. Die letzte ist von 2019. Es war also Zeit, die bisherigen Empfehlungen zu prüfen, ob Änderungen notwendig sind. Folgende Änderungen werden vorgeschlagen:
Erstlinientherapie mit Kombinationen, statt mit Kortison alleine.
Die Wirkstoffe Prednison, Prednisolon, Dexamethason u.a. werden von Medizinern als „Kortison“, „Steroide“ oder „Kortikosteroide“ bezeichnet. Sie sind seit 60 Jahren die erste Therapie für alle behandlungsbedürftigen ITP Patienten (sog. Erstlinien Therapie). Kortison erreicht aber nur bei einem Teil der Patienten eine Rückbildung der Erkrankung. 40-60% bekommen einen Rückfall bzw. sprechen erst gar nicht an und müssen mit einem Zweitlinien-Präparat weiterbehandelt werden. In Deutschland sind das meist Thrombopoetin-Rezeptor-Agonisten, in den USA gerne auch der Antikörper Rituximab. Die Präparate wurden bisher nacheinander gegeben.

Die Experten der ASH Leitlinie empfehlen jetzt (Audia S in der „Updated ASH Clinical Practice Guidelines on Immune Thrombocytopenia (ITP) in Adults, Special-Interest Session“), in der Erstlinie Kortison und einen Thrombopoetin-Rezeptor-Agonisten oder Kortison und Rituximab gleich vom ersten Tag an zu kombinieren. Dadurch kann die Zahl der Rückfälle reduziert, bzw. die Zahl der Patienten, die nach der Erstlinie nicht mehr weiterbehandelt werden müssen ist höher.
Die Autoren sind der Meinung, dass das ein guter Vorschlag ist. Es ist immer von Vorteil, wenn die Zahl der Therapieversager möglichst gering ist. Die Nebenwirkungen der Kombinationen sind auch nicht so viel höher als mit Kortison alleine. Das Problem ist die fehlende arzneimittelrechtliche Zulassung in Deutschland für die Kombination von Kortison + Thrombopoetin-Rezeptor Agonisten oder Kortison + Rituximab in der Erstlinie. Man müsste dann einen Kostenübernahmeantrag schreiben und die Antwort der Krankenkasse abwarten. Das kostet Zeit; solange kann man meist nicht warten. Fazit: Guter Vorschlag aber in Deutschland wohl nicht umzusetzen (siehe dazu auch den Beitrag „Kortison plus Thrombopoetin-Rezeptor-Agonist (TPO-RA) als Erstlinientherapie bei neu diagnostizierter ITP“, weiter unten). Alternativ könnte man in Deutschland mit Kortison beginnen und wenn die Thrombozyten nach wenigen Tagen, z.B. nach einer Woche mit Kortison alleine, nicht ansteigen, zügig den Thrombopoetin-Rezeptor-Agonisten dazunehmen.
Milzentfernung – auf Impfungen und andere Nebenwirkungen achten.
Die Entfernung der Milz wurde vor über 100 Jahren erstmalig durchgeführt und war die erste Therapie der ITP überhaupt. Heute ist sie in den Hintergrund getreten, weil viele Patienten und Ärzte die Operation vermeiden und erst einmal alle nicht-operativen Therapien probieren möchten. Die American Society of Hematology hatte in den vorhergehenden Leitlinien die Milzentfernung zwar weiterhin empfohlen, aber immer mit der Einschränkung, dass man sie nicht früher als 1 Jahr nach Erkrankungsbeginn (weil nicht wenige Patienten im 1. Jahr und auch ohne Milzentfernung die Erkrankung überwinden können) anbieten sollte.

In der aktuellen 2025er Leitlinie (Arnold D in der „Updated ASH Clinical Practice Guidelines on Immune Thrombocytopenia (ITP) in Adults, Special-Interest Session“) soll stehen, dass man ITP-Patienten nicht nur die nicht-operativen Therapien, d.h. Kortikosteroide, Thrombopoetin-Rezeptor-Agonisten u.a. anbieten soll, sondern weiterhin auch die Milzentfernung. Mancher Patient möchte vielleicht doch früh im Krankheitsverlauf die relativ hohe Chance einer Heilung
(60-70%) nutzen, wenn er auf Kortison und Thrombopoetin-Rezeptor-Agonisten nicht angesprochen hat. Gerade junge Frauen wollen von den Medikamenten wegkommen, bevor sie eine Familie planen. Wenn die Milzentfernung geplant wird, dann soll der betreuende Arzt rechtzeitig an alle Impfungen denken, denn Patienten ohne Milz bekommen leichter Infektionen, z.T. auch lebensbedrohliche Infekte. Auch Thrombosen sind etwas häufiger. Nach einer Milzentfernung sollen ITP-Patienten auch bei guten Thrombozytenwerten weiter regelmäßig vom Arzt gesehen werden, ob Infektionen aufgetreten oder ob weitere Impfungen notwendig sind.
Fazit: Die Milzentfernung ist eine gute Therapie, besonders für Patienten, die ihre Erkrankung frühzeitig loswerden und nicht weiter Medikamente einnehmen möchten. Der Arzt muss auf die Impfungen achten und seine Patienten gut aufklären, was sie im Fall von Fieber oder Infekten machen sollen.
SWITCH – Wenn ein Thrombopoetin-Rezeptor-Agonist versagt, soll man einen anderen probieren, bevor man gänzlich andere Medikamente einsetzt.
Seit 15 Jahren gibt es Thrombopoetin-Rezeptor-Agonisten, die die Thrombozytenbildung stimulieren und bei vielen Patienten einen Anstieg der Thrombozytenzahl erreichen. Ca 1/3 der Patienten entwickelt dann aber doch im weiteren Verlauf wieder einen Abfall der Thrombozyten oder es treten Nebenwirkungen auf. Dann hat man bisher zu einer anderen Substanzgruppe, z.B. zu dem Medikament Fostamatinib gewechselt oder zur Rituximab usw.
In der 2025er Leitlinie (Arnold D in der „Updated ASH Clinical Practice Guidelines on Immune Thrombocytopenia (ITP) in Adults, Special-Interest Session“) wird stehen, dass man, wenn ein Thrombopoetin-Rezeptor-Agonist nicht ausreichend wirksam ist, nicht vertragen wird oder wenn der Patient dies wünscht, zunächst auf einen anderen Thrombopoetin-Rezeptor-Agonisten wechseln sollte (engl. Switch).

Es ist wichtig, diesen Switch mit dem Patienten genau zu besprechen, die Gründe zu dokumentieren und Therapiepausen zwischen den verschiedenen Medikamenten zu vermeiden. Die Thrombozytenzahl sollte beim Switch zunächst engmaschig überwacht werden.
Es ist nicht klar, warum ein zweiter TPO-RA doch noch wirkt, wenn der erste nicht anspricht. Die Erfahrung zeigt aber, dass viele Patienten von einem Switch profitieren. Häufig ist so ein Switch in Deutschland der Wechsel von Romiplostim oder Eltrombopag → Avatrombopag.
Fazit: Die Empfehlung ist richtig und war überfällig. Die Deutsche Onkopedia Leitlinie wird in der nächsten Überarbeitung dazu auch Stellung nehmen.
Daratumumab – eine neue Option bei schwerer ITP

Daratumumab ist ein Medikament, das bestimmte Immunzellen (Plasmazellen) ausschaltet. Diese Zellen bilden Antikörper, die bei ITP die Blutplättchen zerstören. In einer kleinen Studie aus Freiburg (List J et al., Präsentation Nr. 3032) wurden stark vorbehandelte ITP-Patienten mit Daratumumab behandelt. 6 von 10 Patienten zeigten einen deutlichen Anstieg der Thrombozyten. Besonders wichtig: Einige Patienten hatten danach über mehrere Jahre stabile Blutplättchenwerte – ohne weitere ITP-Therapie und ohne schwere Blutungen. Die Behandlung war insgesamt gut verträglich. Schwere Infektionen traten nicht auf. Manchmal dauert es mehrere Wochen, bis die Wirkung einsetzt. Daratumumab ist in Deutschland nur für die Behandlung des Myeloms, einer Art von Blutkrebs, arzneimittelrechtlich zugelassen, nicht für die ITP. Wir möchten Sie aber trotzdem über dieses positive Ergebnis informieren.
Avatrombopag Studie 1 – Wirksam im Alltag
Avatrombopag ist ein weiterer Thrombopoetin-Rezeptor-Agonist, also ein Medikament, das die Bildung von Blutplättchen im Knochenmark anregt. Es wird als Tablette eingenommen. In einer großen Alltagsstudien (AVA 3.5-Studie, Piatek C et al., Präsentation Nr. 2683) mit vielen Patientinnen und Patienten zeigte sich jetzt,
- dass die meisten Betroffenen stabile Blutplättchenwerte erreichen,
- dass Notfallbehandlungen nur noch selten notwendig wurden,
- dass viele Patienten Kortison absetzen konnten.
- Die Behandlung mit Avatrombopag wirkte auch dann noch gut, wenn andere Thrombopoetin-Rezeptor-Agonisten zuvor nicht mehr ausreichend geholfen hatten.
Avatrombopag Studie 2 – Gute Lebensqualität der Patienten
In einer europäischen Studie (ADOPT 4 Studie, Mingot EM et al., Präsentation Nr. 6237) berichteten viele Patientinnen und Patienten, dass sie unter Avatrombopag
- weniger Müdigkeit,
- weniger Schmerzen,
- weniger Angst,
- und eine bessere Leistungsfähigkeit im Alltag und bei der Arbeit
haben.
Beide Avatrombopag Studien zeigen, dass sich nicht nur die Blutwerte, sondern auch die Lebensqualität im Alltag deutlich verbessern können. Sie zeigen außerdem, dass es immer wieder neue und wirksame Behandlungsmöglichkeiten für Menschen mit ITP gibt, auch wenn frühere Therapien oder die bisherigen Thrombopoetin-Rezeptor-Agonisten nicht ausreichend geholfen haben. Welche Therapie für Sie geeignet ist, hängt von vielen Faktoren ab. Bitte sprechen Sie darüber mit Ihrer behandelnden Ärztin oder Ihrem behandelnden Arzt.
Kortison plus Thrombopoetin-Rezeptor-Agonist (TPO-RA) als Erstlinientherapie bei neu diagnostizierter ITP

Bisher gibt man bei einem Patienten mit neu diagnostizierter ITP in der ersten Therapielinie meist nur Kortison (häufig eingesetzte Kortisonpräparate sind z.B. Prednison, Prednisolon oder Dexamethason). In einer internationalen Studie* mit dem Namen RODEX wurde nun untersucht, ob eine Kombination von Kortison plus TPO-RA bereits zu Beginn der Erkrankung bessere Ergebnisse erzielt, als die bisher übliche alleinige Behandlung mit Kortison (Mingot EM et al., Präsentation Nr. 733).
An der Studie nahmen 124 erwachsene Patienten mit neu diagnostizierter ITP teil. Sie wurden in zwei Gruppen eingeteilt: Eine Gruppe erhielt Dexamethason über mehrere kurze Behandlungszyklen. Die andere Gruppe erhielt zusätzlich Romiplostim, ein Medikament aus der Gruppe der TPO-RA, das die Bildung von Blutplättchen im Knochenmark anregt. Beide Therapien waren zeitlich begrenzt, anschließend wurden die Teilnehmenden über mehrere Monate weiter beobachtet.
Die Ärzte wollten heraus finden, wie viele Patienten sechs Monate nach Beginn der Behandlung immer noch stabile Blutplättchenwerte hatten, ohne weitere Medikamente dafür einnehmen zu müssen. Die Studie zeigte, dass dies mit der Kombination aus Romiplostim und Dexamethason deutlich häufiger erreicht wurde, als mit Dexamethason allein (Kombination 60,8% versus Kortison alleine 41.3% der Patienten). Auch sprachen insgesamt mehr Patienten auf die Kombinationstherapie an und (!) die Betroffenen benötigten in der Kombinationsgruppe im Durchschnitt weniger Kortison.
Die Behandlung wurde insgesamt gut vertragen. Die meisten Nebenwirkungen waren typisch für Kortison und unterschieden sich nicht wesentlich zwischen den beiden Behandlungsgruppen.
Fazit: Die Kombination aus Kortison und Romiplostim bei neu diagnostizierter ITP erhöht die Wahrscheinlichkeit nach 6 Monaten eine stabile Krankheitskontrolle, ohne dass der Patient weitere Medikamente einnehmen muss, zu erreichen. Für die Kombination in der Erstlinie besteht derzeit noch keine arzneimittelrechtliche Zulassung in Deutschland. Die vorliegenden Daten stützen jedoch die Empfehlung der deutschen Leitlinie, nach unzureichendem Ansprechen auf Kortison frühzeitig eine Behandlung mit einem TPO-RA einzuleiten.
|
*an der Studie beteiligte Länder |
Ianalumab Studie 1 - Wirksamkeit in der chronischen ITP ab der 3. Therapielinie (VAYHIT3)
In der Studie wurden bei 41 Patienten der Antikörper Ianalumab erstmalig in der ITP untersucht.

Ianalumab verfolgt einen neuen Wirkmechanismus indem es die für die Antikörperbildung notwendigen B-Zellen blockiert und ausschaltet. Der Antikörper wird dabei 4-malig alle 4 Wochen über die Vene verabreicht - also eine zeitlich befristete Therapie. In der Studie wurden bei stark vorbehandelten chronischen ITP-Patienten stabile Anstiege der Blutplättchen in 44% bis hin zu kompletten Remissionen in 9 von 41 der Studienteilnehmenden gezeigt. Außerdem nahmen die Blutereignisse deutlich ab und die Behandlung wurde gut toleriert.
Fazit: Die Studie untermauert die Wirksamkeit dieser neuen Substanz bei guter Verträglichkeit. Besonders von Bedeutung sind dabei, dass es sich um eine zeitlich befristete Therapie handelt und das komplette Remissionen möglich sind.
Ianalumab Studie 2 - Wirksamkeit in der 2.Therapielinie (Rezidiv nach Kortison)
In der Studie wurde bei insgesamt 152 Patienten, die nach einer Kortisontherapie unter 30 Bluttplättchen aufwiesen, die Wirksamkeit einer zeitlich begrenzten Therapie mit 4 Gaben Ianalumab in Kombination mit Revolade, welches nach spätestens 24 Wochen ausschleichend abgesetzt wurde, getestet. Primäres Ziel der Studie war es die Zeit bis zum erneuten Abfall der Blutplättchen (Therapieversagen) im Vergleich zu Placebo zu verlängern. Das konnte eindrucksvoll nachgewiesen werden. Die Zeit bis zum Therapieversagen konnte im Vergleich zu Placebo von 4,7 auf 13 Monate verlängert werden. Auch in dieser Studie wurde der Antikörper Ianalumab gut vertragen.
Fazit: Die Studie konnte eindrucksvoll nachweisen, dass mit einer zeitlich befristeten Therapie mit Ianalumab eine potentiell dauerhafte Krankheitskontrolle mit einer gut verträglichen Therapie möglich ist. Besonders der krankheitsmodifzierende Effekt der Therapie macht hierbei besondere Hoffnung für eine neue Therapieoption in der ITP.
Autoren des ITP ASH-Kuriers für Patienten
![]() |
Dr. med. Rosa Sonja Alesci Fachärztin für Innere Medizin mit Weiterbildungsermächtigung und Prüferin für Hämostaseologie und zertifizierte Gesundheitsökonomin. Sie ist Ärztliche Leiterin des IMD Gerinnungszentrums Hochtaunus am Gesundheitscampus Bad Homburg und Mit-Autorin der DGHO Onkopedia Leitlinie ITP.
|
![]() |
Prof. Dr. med. Axel Matzdorff Facharzt für Innere Medizin mit dem Schwerpunkt Hämatologie und Onkologie und Hämostaseologie. Er leitet die hämatologisch-onkologische Ambulanz des Werner Forßmann Krankenhauses in Eberswalde und ist Mit-Autor der DGHO Onkopedia Leitlinie ITP.
|
![]() |
Dr. med. Thomas Stauch Hämatologe und Onkologe am Universitätsklinikum Jena mit Schwerpunkt Immunthrombozytopenie. Er ist Gründer der Deutschen ITP-Allianz und Leiter des D.ITP-Registers. Er ist Letztautor und nächster Erstautor der DGHO Onkopedia Leitlinie ITP. |
![]() |
Dr. med. Karolin Trautmann-Grill Fachärztin für Hämatologie und Onkologie, Schwerpunktbezeichnung Hämostaseologie. Arbeitet als Oberärztin in der Medizinischen Klinik I des Universitätsklinikums Dresden an der TU Dresden und leitet dort die hämatologische Ambulanz. Sie ist Erstautorin der DGHO Onkopedia Leitlinie ITP und Mit-Initiatorin des deutschen ITP-Registers und der deutschen ITP-Allianz. |




